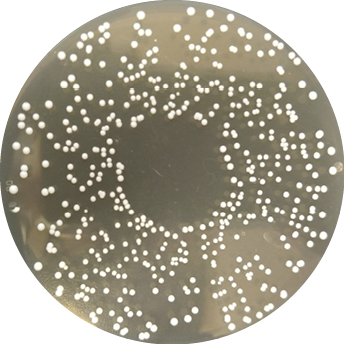

Objemové krmivá sú položkou číslo jedna v kŕmnej dávke dojníc a rastie aj ich podiel v kŕmnych dávkach mäsového dobytka. Kľúčom k dosiahnutiu vysokej ziskovosti je vyťažiť maximum z každej tony zozbieranej krmovín a uchovať jej nutričnú hodnotu. Aj keď je konzervácia krmovín fermentováním starodávnu metódou, predstavuje dnešné výroba silážou technologicky vyspelý proces.

Nové technológie umožnili porozumieť mechanizmu pôsobenia silážnych inokulant, rovnako tak ako nachádzať nové bakteriálne kmene, ktoré budú lepšie riešiť problémy, s ktorými sa výrobcami silážou stretávajú počas súčasných výrobných postupov. Príkladom je prípravok novo uvedený na trh, obsahujúci baktériu, ktorá bola vyselektované pre svoju výnimočnú schopnosť zlepšovať aeróbne stabilitu väčšiny silážou: Lactobacillus hilgardii CNCM I-4785.
Maximálne využitie každého kilogramu siláže vďaka lepšej aeróbne stabilite
Silážovanie je anaeróbny proces, ktorý spočíva v premene cukrov na organické kyseliny, predovšetkým kyselinu mliečnu, octovú a propionovú. Tieto organické kyseliny sú produkované baktériami, ktoré sa prirodzene nachádzajú na rastlinách alebo sú do silážovaného materiálu pridávané ako biologické konzervanty čiže inokulant. Proces možno rozdeliť do troch hlavných fáz:
1) fermentácie - aktívnej mikrobiálnej fázy; vďaka činnosti baktérií mliečneho kvasenia klesá pH a spotrebováva sa kyslík,
2) skladovanie - stabilný obdobia; po dosiahnutí finálneho pH je utlmená všetka mikrobiálna aktivita,
3) vyberanie siláže - mikroorganizmy sú znovu aktivované po vystavení kyslíka.
V priebehu vyberaní siláže sa nežiaduce mikroorganizmy, ako sú plesne a kvasinky, znovu aktivujú a siláž sa začne zahrievať, čo vedie k stratám sušiny siláže, fenoménu známemu ako aeróbna nestabilita. Tento proces spôsobuje veľké straty pre farmára. V závislosti na plodine a technológii silážovanie môžu straty v dôsledku aeróbnej nestability dosahovať až 15% sušiny. Zahrievaním siláže sa doslova spáli živiny. Nestabilná siláž tiež spôsobuje zníženie príjmu krmiva zvieratami, má nízku kŕmnu hodnotu a predstavuje potenciálne riziko vďaka prítomnosti plesní a mykotoxínov.
Objavenie vysoko špecifické baktérie mliečneho kvasenia Lactobacillus Buchner NCIMB 40788 spoločností Biotal vo Veľkej Británii v deväťdesiatych rokoch minulého storočia predstavovalo skutočný prielom v oblasti silážnych inokulant zvyšujúcich aeróbne stabilitu siláží. Stal sa prvým inokulant registrovaným v Európskej únii, a bol tiež schválený americkou FDA v roku 1996 ako preukázateľne zvyšujúce aeróbne stabilitu.
Od svojho uvedenia na trh L. Buchner NCIMB 40788 úspešne zlepšoval aeróbne stabilitu siláže u širokej škály krmovín v najrôznejších podmienkach. Aby bol výsledok silážovanie optimálne, je však potrebné 60 dní fermentácie. Vedci verili, že by mohli ďalej zvýšiť účinnosť kmeňa L. Büchner NCIMB 40788, keby ho mohli kombinovať s inou, kompatibilný baktérií. Nastal čas hľadať nové baktérie, ktoré by mohli pomôcť L. Buchner NCIMB 40788 podporovať aeróbne stabilitu rýchlejšie a po dlhšiu dobu, čo by farmárom poskytlo vyššiu flexibilitu a zároveň zabezpečilo lepšie uchovanie kŕmne hodnoty silážovanej plodiny.

Nájdenie ihly v kope sena alebo umenie bakteriálneho skríningu
Vedci v oblasti silážovanie vedeli, čo konkrétne hľadajú, ale výzvou bolo určiť, kde presne nový bakteriálne kmeň hľadať.
Odpoveď prišla z Brazílie. U siláže z cukrovej trstiny je veľmi ťažké dosiahnuť aeróbne stabilitu, ale vedci z Federálnej univerzity v Lavras v Minas Gerais, brazílskom štátu s najvyššou produkciou mlieka, našli prirodzene stabilné trstinovou siláž. Vykonali jej mikrobiálne skríning a hľadali nové bakteriálne kmene vhodné ako silážnej inokulant. Spoločnosť Lallemand Animal Nutrition sa pripojila k spoločnému vedecko-výskumnému projektu, aby tiež ťažila z tohto zaujímavého výskumu.
V priebehu skríningu bolo izolovaných 81 rôznych kmeňov a tie boli potom vyšetrované na schopnosť rastu v podmienkach výroby siláží. Boli testované ich fermentačnej vlastnosti a samozrejme schopnosť konzervácie a zlepšovanie aeróbne stability trstinovej siláže.
Nakoniec bolo vyselektované 14 kmeňov, ktoré boli podrobené DNA sekvenovanie a klasifikované ako príslušníci troch druhov rodu Lactobacillus: L. plantarum, L. brevis a L. hilgardii. Pri každom z vybraných kmeňov bola hodnotená schopnosť fermentácie, zlepšovanie aeróbne stability, obmedzenie počtov kvasiniek a plesní a zníženie strát sušiny v laboratórnych silážnych nádobách v experimentoch s dĺžkou 61 a 126 dní.
Na základe tohto funkčného skríningu boli vybrané iba dva kmene: UFLA SIL 51 a L. hilgardii CNCM I-4785.
Tieto kmene boli potom ďalej testované na rôznych krmoviny, ako samostatne, tak v kombinácii s L. Buchner NCIMB 40788. Cieľom bolo zabezpečiť, aby oba kmene dokázali zlepšovať aeróbne stabilitu cukrovej trstiny a ďalších krmovín, a predovšetkým boli účinné nielen v ranej fáze fermentačného cyklu , ale aj dlhodobo. Pokusy s oboma kmeňmi boli vykonané v Severnej Amerike a v Európe na siláž z kukurice, ciroku a celých rastlín obilnín.
Metaanalýza deviatich pokusov ukázala, že L. hilgardii CNCM I-4785 významne zlepšil aeróbne stabilitu už po 15 dňoch fermentácie, a tiež výrazne zvýšil stabilitu po 30 a po 100 dňoch siláže v kombinácii L. Buchner NCIMB 40788 u rady krmovín (pozri tabuľku).

Z laboratória na farmu
Od svojho objavenia na Federálne univerzite v Lavras v Brazílii takmer pred desiatimi rokmi bol L. hilgardii CNCM I-4785 skúmal v štúdiách nezávislých tretích strán. Komerčné pokusy boli vykonané v Severnej Amerike a v Európe, aby bolo preukázané, že L. hilgardii CNCM I-4785 v kombinácii s L. Buchner 40788 bude fungovať aj mimo experimentálne podmienky.
Európsky úrad pre bezpečnosť potravín (EFSA) udelil povolenie používať L. hilgardii CNCM I-4785 ako silážne biologický konzervant v Európe. Spoločnosť Lallemand Animal Nutrition začal predávať silážne inokulant prémiovej rady MAGNIVA, ktoré obsahujú oba tieto kmene, v Európe a v Austrálii, kde boli tiež vykonané terénne pokusy.

Nové silážne portfólio
Silážne prípravky radu MAGNIVA je možné rozdeliť do dvoch produktových radov: Classic a Platinum. Rad Classic je založená na kombinácii homofermentativních baktérií mliečneho kvasenia, enzýmov a špeciálnym kmeňa Propionibacterium acidipropionici. Z toho jasne vyplýva ich zameranie na rýchlu primárnej fermentácii maximálne obmedzujúce straty a zároveň zvýšenie stráviteľnosti organickej hmoty.
MAGNIVA Classic prináša siláž so zväčšenou ochranou sušiny a vyššou nutričnou hodnotou, predovšetkým z trávnych porastov, luskoobilných zmesiek alebo GPS. Svoju účinnosť stavia na kombináciu bakteriálnych kmeňov Pediococcus pentosaceus a Lactobacillus plantarum spolu s enzýmami beta-glukanáza, ktorá pomáha uvoľniť cukry z krmiva, a tým zabezpečuje rýchlu fermentáciu, a xylanázy, ktorá zvyšuje stráviteľnosť siláže.

MAGNIVA Classic + by Sil-All zaisťuje zachovanie maxima sušiny a živín v ťažko silážovatelných plodinách, typicky siláž z lucerny a ďateliny. Prípravok využíva špecificky vybrané kmene baktérií mliečneho kvasenia Pediococcus pentosaceus, Pediococcus acidilactici a Lactobacillus plantarum, spolu s vysoko aktívnymi enzýmami beta-glukanáza a xylanáza. Tento produkt je k dispozícii aj vo variante pre ekologické poľnohospodárstvo pod označením MAGNIVA Classic + by Sil-All for organic use.

MAGNIVA Silver + by Sil-All sa zameriava na plodiny s vysokým obsahom cukrov a variabilný sušinou pri zbere s ohľadom na maximálnu zachovanie sušiny, živín a zvýšením stability pri odbere. Medzi cieľové plodiny patrí kukurica a cirok. Produkt využíva kombináciu baktérie mliečneho kvasenia Pediococcus acidilactici a špeciálneho kmeňa Propionibacterium acidipropionici prinášajúci dokončenie a zvýšenie aeróbnej stability pri zachovaní vysokej chutnosti výslednej siláže, doplnený o enzým alfa-amyláza s dopadom na zrýchlenie primárnej fermentácie a zároveň skrátenie obdobia na dosiahnutie plnej stráviteľnosti škrobu.
Prémiová rada silážnych inokulant Platinum je založená na vyššie spomínanom patentovanom riešenie kombinácie nového kmeňa Lactobacillus hilgardii CNCM I-4785 a dlhodobo overenom kmeňu Lactobacillus Buchner NCIMB 40788. Synergický účinok týchto dvoch kmeňov je využívaný vo všetkých troch produktoch:

MAGNIVA Platinum 1 stavia plne na tejto novej technológii so zameraním na plodiny s vysokým obsahom cukrov (kukurica, cirok) a prináša bezkonkurenčnú stabilitu výslednej siláže a flexibilitu skrmovanie. Siláž je tak stabilný a pripravená ku skrmovanie už po 15tich dňoch a jej stabilita ďalej rastie pri dlhodobejšom skladovaní. Spoločné pôsobenie oboch kmeňov tak výrazne presahuje funkčnosť jednotlivých kmeňov zvlášť. Toto bolo dlhodobo overované a v súčasnej dobe sa jedná o vedecky overené riešenie prinášajúce úplne nový prístup v silážovanie.

MAGNIVA Platinum 2 využíva kombináciu kmeňov Lactobacillus hilgardii CNCM I-4785, Lactobacillus Buchner NCIMB 40788 a je doplnený o homofermentativní kmeň Pediococcus pentosaceus. Uplatnenie nájde u plodín s relatívne vysokým obsahom cukrov, stredne ťažko silážovatelných, ako napríklad siláže z kukurice, trávnych porastov s vysokým obsahom cukrov, luskoobilných zmesiek alebo GPS. Prípravok bol overovaný aj pre ošetrenie mačkaného zrna kukurice, kde je schopný zabezpečiť dlhodobú aeróbne stabilitu za súčasného obmedzenia množstva kvasiniek.

MAGNIVA Platinum 3 je postavený na rovnakej kombinácii baktérií mliečneho kvasenia ako MAGNIVA Platinum 2 a doplnený o zmes enzýmov beta-glukanáza a xylanáza, ktoré majú za úlohu zrýchliť samotnú fermentáciu, a súčasne aj zvýšiť stráviteľnosť siláže. Využitie nachádza predovšetkým pre krmoviny s vysokým obsahom dusíkatých látok a nízkou hladinou cukrov (lucerna, ďatelina) s výrazným dopadom na aeróbne stabilitu pri skrmovaní.
Nové silážne inokulant MAGNIVA boli vyvinuté, aby cielene riešili špecifické problémy, ktorým čelíme pri rôznych typoch krmoviny, predovšetkým v dvoch kritických obdobiach - priebeh rýchle primárnej fermentácie a stabilita pri skrmovaní. Medzi ďalšie benefity patrí zabezpečenie dostatočných zásob stabilného, vysoko kvalitného krmiva s vysokým potenciálom príjmu, poskytnutie základu vyrovnanej kŕmnej dávky a vylepšenia návratnosti nákladov na výrobu objemových krmív.





